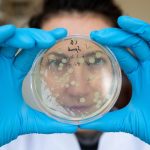
2185705_profimedia0507726849-rusija_ls

U trendu
Pratite
Spavajte bolje i slađe: 6 namirnica koje čine čuda za san
Admin -
0
Namirnice koje čine čuda za san
Ishrana igra ključnu ulogu u kvalitetu sna. Ove namirnice, poput mleka, badema i čaja od kamilice, mogu pomoći da...